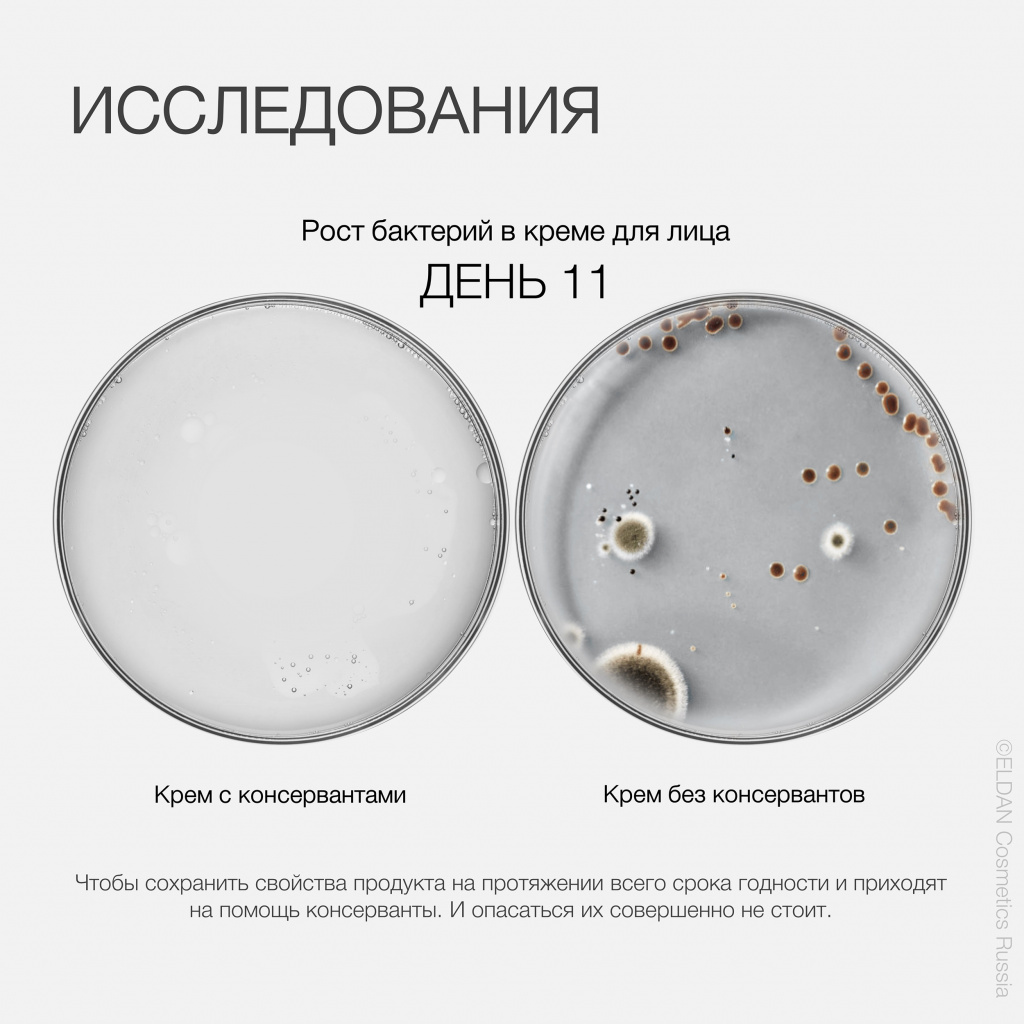
Пост консерванты 3.jpg

Консерванты в косметике
|
Вопрос безопасности косметических средств всегда актуален, потому что тот или иной крем или сыворотка находятся на нашем лице 24/7 и очень важно быть уверенным, что помимо увлажнения и омоложения, нет никаких опасных накопительных эффектов. Особенную озабоченность вызывают консерванты. В интернете очень много статей про вред и безопасность этих ингредиентов, но можно легко запутаться, т.к. часто различные источники противоречат друг другу. В том, что консерванты необходимы, нет никаких сомнений, ведь размножение микроорганизмов в косметическом продукте способно нанести серьезный вред здоровью. С другой стороны, в современном мире есть четкая тенденция к предпочтению максимально натуральных продуктов. В бьюти-сфере это нашло отражение в появлении органической косметики. |
![]() |
![]() |
ИССЛЕДОВАНИЯВ органической косметике нет парабенов, феноксиэтанола, силиконов, ПЭГ, синтетических отдушек и красителей, минерального масла, продуктов животного происхождения. Это прекрасные, безопасные продукты, но часто недостаточно эффективные.Например, есть марки косметики с биокомплексами или с экстрактом плаценты, и они дают потрясающие эффекты именно из-за ингредиентов, которые исключают их «органичность». Много шума в свое время наделали парабены (эфиры парагидроксибензойной кислоты) Исследования выявили их эстрогеноподобную активность и вклад в развитие гормонозависимых опухолей. Но парабенов очень много и все они разные, поэтому появилась группа запрещенных парабенов и тех, чей вред не подтвердился. Нужно заметить, что у институтов разных стран на конкретные парабены мнение может отличаться! |
КАКИЕ ВЫВОДЫ МОЖНО СДЕЛАТЬ?
|
![]() |
Рекомендуемые товары
Узнать цену
Узнать цену
Узнать цену
4 824 /шт
5 360
-10%
Экономия 536
Варианты цен
4 824 /шт
5 360
-10%
Экономия 536
В корзину
В корзине
Узнать цену
Узнать цену
Сообщить о поступленииОтписаться
Узнать цену
Узнать цену
Узнать цену
Узнать цену
Узнать цену
Сообщить о поступленииОтписаться
Узнать цену
4 766 /шт
5 295
-10%
Экономия 529
Варианты цен
4 766 /шт
5 295
-10%
Экономия 529
В корзину
В корзине
Узнать цену
похожие статьи
подпишитесь на рассылку
Оставайтесь в курсе эксклюзивных предложений и новейшей информации о продукте с нашей рассылкой.